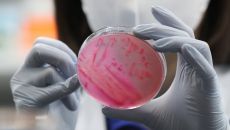

이슈뉴스
-

함평군, 어린이집 아동·교사 대상 '감염병 예방' 교육 운영
[더팩트ㅣ함평=김동언 기자] 전남 함평군이 7~8월 여름철 감염병 위험이 높아짐에 따라 관내 어린이집 아동과 교사를 대상으로- 2025.07.14 10:01
- 더팩트
-

코바코, 국내 기업 '중국 현지 마케팅' 돕는다
(서울=연합뉴스) 나확진 기자 = 한국방송광고진흥공사(코바코)가 국내 기업의 해외시장 진출을 돕고자 진행 중인 해외마케팅 지원- 2025.07.14 09:55
- 연합뉴스
-

경기도, 경기 청년 축산물 밀키트 개발 컨설팅 사업 참가자 모집
8월 11일까지, 10개 팀 선발…청년 일자리 창출, 축산업 활력 도모 시장분석부터 실제 시제품 개발까지…창업 전 과정 포함- 2025.07.14 09:27
- 더팩트
-

경기 양계농가 4만여마리 폭염 피해…도, 면역증강제 추가 지원
(의정부=연합뉴스) 우영식 기자 = 경기도는 폭염으로 축산농가 피해가 우려됨에 따라 더위에 취약한 양계농가에 면역증강제 20t- 2025.07.14 09:27
- 연합뉴스
-

양천구 "방학 끼니 걱정 없도록"…여름방학 아동급식 지원
양천구(구청장 이기재)는 여름방학 동안 학교급식이 중단되며 발생할 수 있는 급식 공백을 해소하기 위해, 지역 내 취약계층 아동- 2025.07.14 09:18
- 연합뉴스
-

경기도, 양계 농가 폭염 피해 예방 '면역증강제' 긴급 추가 지원
13개 시·군 총 41건 약 5만 두 피해 접수…파주시 1만 5536두 긴급가축방역비 지원…5월 비타민·광물질 등 지원 후속- 2025.07.14 09:17
- 더팩트
-

"방학에도 끼니 걱정 없도록"…양천구 취약층 아동에 급식 지원
(서울=연합뉴스) 정준영 기자 = 서울 양천구(구청장 이기재)는 여름방학 기간 학교급식 공백을 해소하고자 지역 취약계층 아동- 2025.07.14 09:10
- 연합뉴스
-

함평군,'2026년 취약지역 생활여건 개조사업' 최종 선정
전남 함평군(군수 이상익) 함평읍 장고산마을 주민이 ‘2026년 취약지역 생활여건 개조사업’에 공모에 주도적으로 참여해 최종- 2025.07.14 08:38
- 아주경제
-

"음식에 벌레, 환불해줘" 업주 305명 당했다…'자작극' 20대 최후
"배달 음식에서 벌레가 나왔다"는 자작극으로 자영업자 305명으로부터 770여만원을 환불 받은 대학생이 징역 1년을 선고 받았- 2025.07.14 08:17
- 머니투데이
-

5월부터 온열질환자 6배↑[위기의 노동자]②
지난 5월에만 온열질환자가 5년 전보다 6배 증가한 것으로 드러났다. 대부분은 실외에서 장시간 노동을 하다 고온에 노출됐으며,- 2025.07.14 07:19
- 아시아경제
-

경기도, 양계농가에 면역증강제 20t 긴급 지원…폭염 피해 선제 대응
경기도는 연일 계속되는 폭염으로 축산농가 피해가 우려됨에 따라 더위에 특히 취약한 양계농가를 대상으로 20t 상당의 면역증강제- 2025.07.14 07:11
- 아시아경제
-

"배달음식에 벌레" 자작극 벌여 305차례 환불…대학생 실형
"배달 음식에서 벌레가 나왔다"는 자작극을 300여차례나 벌여 자영업자들을 상대로 돈을 뜯어낸 20대가 1심에서 실형을 선고받- 2025.07.14 06:56
- 연합뉴스TV
-

[팩트체크] '2시간 일하면 20분 휴식' 의무화…각국 폭염 노동자 안전 고심
(서울=연합뉴스) 구정모 기자 = 이번 주부터 폭염 때 2시간 일하는 노동자에게 일정 시간 이상 휴식이 의무화된다. 지난 11- 2025.07.14 06:55
- 연합뉴스
-

폭염에도 샤워 거부, 무좀 긁고 애 만지는 남편…"더러워서 이혼하고 싶어"
깔끔한 줄 알았던 남편이 결혼 후엔 돌연 위생관념이 사라져 괴롭다는 한 여성의 사연이 전해졌다. 지난 11일 JTBC '사건반- 2025.07.14 05:58
- 머니투데이
-

“배달 음식에 벌레 나왔다” 305차례 환불…자영업자 울린 대학생 죗값은?
배달 음식에서 벌레가 나왔다고 속여 305차례에 걸쳐 770만원이 넘는 음식값을 환불 받은 20대 대학생이 실형을 선고 받았다- 2025.07.14 05:36
- 세계일보
-

폭염속 식중독 비상… 김밥집 130명-학교 급식 73명 집단 발병
서울 서대문구에 거주하는 직장인 김수연 씨(29)는 7월 초 생전 처음 식중독으로 의심되는 구토 증상과 복통을 겪었다. 통증이- 2025.07.14 03:00
- 동아일보
-

“어제 씻었잖아” 폭염에도 샤워 거부··· 아내 “더러워서 못 살아”
결혼 후 위생 관념이 사라진 남편 때문에 괴로움을 호소하는 한 여성의 사연이 전해졌다. 11일 전파를 탄 JTBC ‘사건반장’- 2025.07.13 22:23
- 서울경제
-

팬데믹 끝나자… 청소년 약물 경험 더 크게 늘었다
청소년의 약물 사용 경험이 코로나19 팬데믹 때 일시적으로 줄어들었다가 일상 회복 이후 더 큰 폭으로 반등한 것으로 나타났다.- 2025.07.13 19:07
- 세계일보
-

"배달 음식에 벌레 나왔어요" 신고했다가 징역형…알고보니 수백 차례 자작극
배달 음식에 벌레가 들어갔다며 수백회 자작극을 벌여 자영업자들에게 돈을 뜯어낸 20대 대학생이 1심에서 실형을 선고받았다. 1- 2025.07.13 18:37
- 아시아경제
-

“음식에 벌레”…자영업자 305명 울린 대학생 실형
[이데일리 박정수 기자] 배달 음식에 벌레가 들어 있다는 거짓말로 자영업자 305명을 협박해 돈을 뜯어낸 20대가 1심에서 실- 2025.07.13 18:23
- 이데일리
-

"음식에 벌레" 자작극 벌여 305차례 환불…대학생 실형
"배달 음식에서 벌레가 나왔다"는 자작극을 300여차례나 벌여 자영업자들을 상대로 돈을 뜯어낸 20대가 1심에서 실형을 선고받- 2025.07.13 18:22
- 연합뉴스TV
-

"배달음식에 벌레" 305차례 환불…자영업자 울린 대학생 실형
(서울=연합뉴스) 최원정 기자 = "배달 음식에 벌레가 들어있다"는 등의 자작극을 300여차례 벌여 자영업자들을 상대로 돈을- 2025.07.13 18:13
- 연합뉴스
-

폭염 속 온열질환자 1523명·사망자 9명…남성·고령·야외노동자 집중
질병청 "무더위·열대야 지속…야간에도 각별한 주의 필요" [더팩트ㅣ김영봉 기자] 폭염이 이어지면서 온열질환자가 1500명을 넘- 2025.07.13 17:41
- 더팩트
-
때이른 더위에 식중독 기승…김밥집·학교 등 집단감염 속출
서울 서대문구에 거주하는 직장인 김수연 씨(29)는 7월 초 생전 처음 식중독으로 의심되는 구토 증상과 복통을 겪었다. 통증이- 2025.07.13 17:36
- 동아일보
-

[프로필]임승관 질병청장, 코로나19 현장서 싸운 '감염병 전문가'
신임 질병관리청장으로 발탁된 임승관(51) 국립중앙의료원 중앙감염병원 설립추진단장은 코로나19 확산기에 지역 방역 최전선에 섰- 2025.07.13 17:22
- 아시아경제

